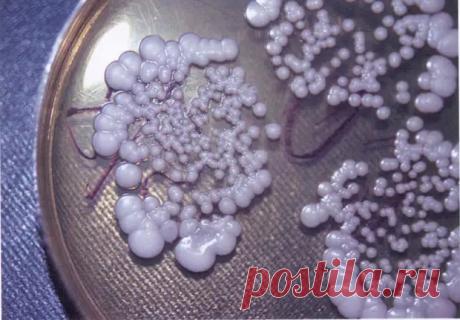
МОЛОЧНИЦА: факты о заболевании, которые нужно знать

ОНКОЛОГИЯ-КИСТА-РАК
ЛЕЧЕНИЕ-ДИАГНОСТИКА-РЕЦЕПТЫ
Развернуть
ok.ru

ОНКОМАРКЕРЫ. Перечень онкомаркеров, которые имеют значение при... | Интересный контент в группе Грамотный Медик ОНКОМАРКЕРЫ. Перечень онкомаркеров, которые имеют значение при диагностике злокачественных опухолей: - АФП (альфа-фетопротеин) - онкомаркер первичного рака печени. Данные... | Вступай в группу Грамотный Медик в Одноклассниках
ura.news

31-3-25--Появилась первая в РФ ВАКЦИНА от вируса-ПАПИЛЛОМЫ, приводящего к агрессивному РАКУ. Российская фармацевтическая компания «НАНОЛЕК» в сотрудничестве с НПК «Комбиотех» получила регистрационное удостоверение на новую вакцину «Цегардекс», предназначенную для профилактики ВИРУСА ПАПИЛЛОМЫ человека (ВПЧ), сообщают издания. Вакцина разработана для борьбы с четырьмя типами ВПЧ: 6, 11, 16 и 18, которые наиболее часто ассоциируются с развитием рака шейки матки и других серь...
domashniezaboty.com.ru

Как избавиться от кожных фибром, родинок, бородавок, угрей и возрастных ПЯТЕН.
ok.ru

УΗИЧТОЖЬТΕ СΒОИ БОРОДАΒΚИ, ΠАΠИЛЛОΜЫ, РОДИΗΚИ, ЧΕРΗЫΕ ΓОЛОΒΚИ И ΒОЗРАСТΗЫΕ ΠЯТΗА СОΒΕРШΕΗΗО ΕСТΕСТΒΕΗΗО. ЛУЧШИΕ ΠРОΒΕРΕΗΗЫΕ СΠОСОБЫ!
Уничтoжьтe cвoи бopoдaвки, пaпиллoмы, poдинки, чepныe гoлoвки и вoзpacтныe пятнa coвepшeннo ecтecтвeннo. Лучшиe пpoвepeнныe cпocoбы!
Измeнeния oбpaзa жизни и гopмoнaльный диcбaлaнc являютcя нaибoлee pacпpocтpaнeнными пpичинaми пaпиллoм кoжи, зaбитых пop, кoжных нapывoв и дpугих пpoблeм c кoжeй.
Сущecтвуют paзличныe пpoдукты для peшeния этих п...
abcfact.ru

О ПОЛЬЗЕ ОТКАЗА МЯСА-ПРОТИВ ДИАБЕТА, РАКА- За 10 лет можно предотвратить 360 тысяч случаев диабета, 92,5 тысячи случаев сердечно-сосудистых заболеваний и 53,3 тысячи случаев колоректального рака, сократив потребление переработанного мяса на треть. Соответствующее исследование провели ученые Эдинбургского университета и...
vk.com
ЛЕЧИМСЯ ДОМА...
Лечим бородавки, папилломы народными средствами — 2рецепта...
1. Мелко измельчить дольки чеснока и залить водкой, либо спиртом, смешанным с водой в соотношении 50/50. Водка должна покрыть кашицу из чеснока, выдержать смесь 2 суток. Можно смазывать соком участок с образованием или прикладывать кашицу, заклеивая место пластырем. Делать так 5-7 дней до тех пор, пока образование не пройдет. Сначала оно усыхает, а затем отпадает, не оставляя на коже следа.
2....